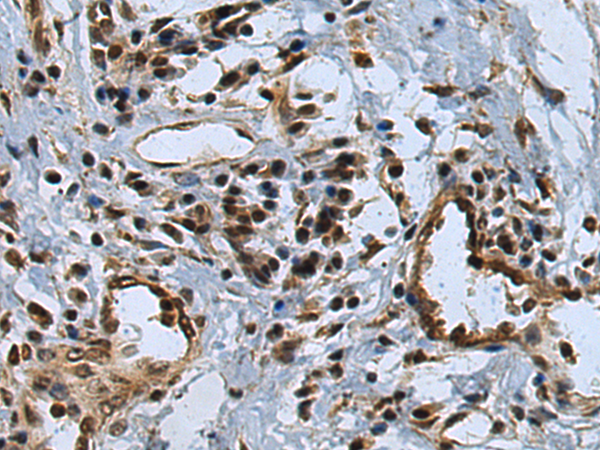
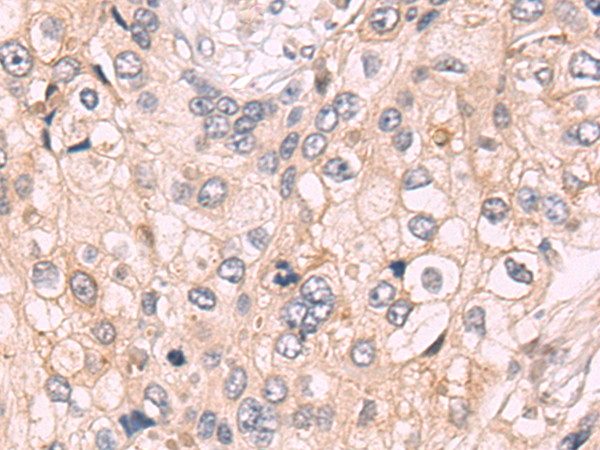

-
分类: 科研抗体货号: P10721别名: HBGF-5; TCMGLY; Smag-82应用: IHC反应种属: Human
-
分类: 科研抗体货号: P10674别名:应用: WB,IHC反应种属: Human, Mouse, Rat
-
分类: 科研抗体货号: P10698别名: AAA; AD1; PN2; ABPP; APPI; CVAP; ABETA; PN-II; preA4; CTFgamma应用: WB,IHC反应种属: Human, Mouse, Rat
-
分类: 科研抗体货号: P10720别名: INT2; HBGF-3应用: WB,IHC反应种属: Human, Rat
-
分类: 科研抗体货号: P10673别名: RABL; L1880; RAB5L; RAB5CL应用: WB,IHC反应种属: Human, Mouse
-
分类: 科研抗体货号: P10696别名: APG4B; AUTL1应用: WB反应种属: Human, Mouse
-
分类: 科研抗体货号: P10719别名: AFGF,ECGF,ECGF-beta,ECGFA,ECGFB,FGF-alpha,FGFA,GLIO703,HBGF1应用: IHC反应种属: Human, Mouse, Rat
-
分类: 科研抗体货号: P10672别名: RAB5应用: WB反应种属: Human, Mouse, Rat
-
分类: 科研抗体货号: P10693别名: ANPa, NPRA, ANPRA, GUC2A, GUCY3A应用: IHC反应种属: Human, Mouse, Rat
-
分类: 科研抗体货号: P10718别名: BFGF; FGFB; FGF-2; HBGF-2应用: WB,IHC反应种属: Human, Mouse, Rat

鄂公网安备42018502007531号
鄂公网安备42018502007531号

